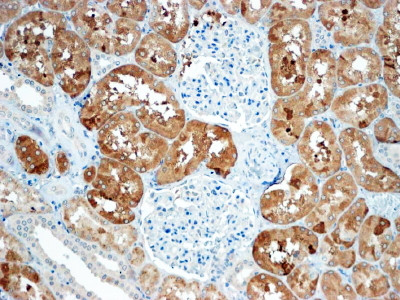
Sclerostin Antibody in Immunohistochemistry (Paraffin) (IHC (P))

Search
Invitrogen
Sclerostin Polyclonal Antibody
{{$productOrderCtrl.translations['antibody.pdp.commerceCard.promotion.promotions']}}
{{$productOrderCtrl.translations['antibody.pdp.commerceCard.promotion.viewpromo']}}
{{$productOrderCtrl.translations['antibody.pdp.commerceCard.promotion.promocode']}}: {{promo.promoCode}} {{promo.promoTitle}} {{promo.promoDescription}}. {{$productOrderCtrl.translations['antibody.pdp.commerceCard.promotion.learnmore']}}
图: 1 / 1
Sclerostin Antibody (PA5-37943) in IHC (P)

Please note: We are reviewing Western blot images included in the antibody testing data in our catalog, including those provided by third parties. Unless expressly labeled or annotated as “raw-unedited”, Western blot images included in the antibody testing data in our catalog may have been edited, optimized or otherwise adjusted for presentation.
产品信息
PA5-37943
种属反应
宿主/亚型
分类
类型
抗原
偶联物
形式
浓度
规格
纯化类型
保存液
内含物
保存条件
运输条件
RRID
产品详细信息
This antibody is predicted to react with mouse, rat, dog and cow based on sequence homology.
This antibody is tested in Peptide ELISA: antibody detection limit dilution 32,000.
靶标信息
Sclerostin, a glycoprotein predominantly secreted by osteocytes, is a member of the Cerberus/DAN family of putative BMP antagonists that functions as an endogenous regulator of the canonical Wnt signaling pathway and an inhibitory regulator of bone homeostasis. Although expressed nearly exclusively by osteocytes, sclerostin can also be found at significant levels elsewhere, such as bone, bone marrow, cartilage, the kidney, and the liver, and has also been shown to be produced by hypertrophic chondrocytes and cementocytes. Like DKK family members DKK-1 and DKK-4, sclerostin plays an important regulatory role in the Wnt/beta-catenin signaling pathway by forming inhibitory complexes with LDL Receptor-related proteins 5 and 6 (LRP5 and LRP6), which are essential components of the Wnt/beta-catenin signaling system. LRP5 and LRP6 are single-pass transmembrane proteins that appear to act as co-receptors for Wnt ligands involved in the Wnt/beta-catenin signaling cascade. Sclerostin has also been shown to interact directly with LRP4 via its extracellular domain to facilitate inhibition of Wnt signaling, and can catabolically promote osteoclast activity by increasing osteocyte expression of RANKL. Sclerostin's critical involvement in the regulation of bone formation and resorption is emphasized by two bone dysplasia disorders, sclerosteosis and van Buchem disease (VBD), caused by rare autosomal recessive mutations that result in progressive bone overgrowth and hypermineralization due to markedly decreased sclerostin levels.
仅用于科研。不用于诊断过程。未经明确授权不得转售。